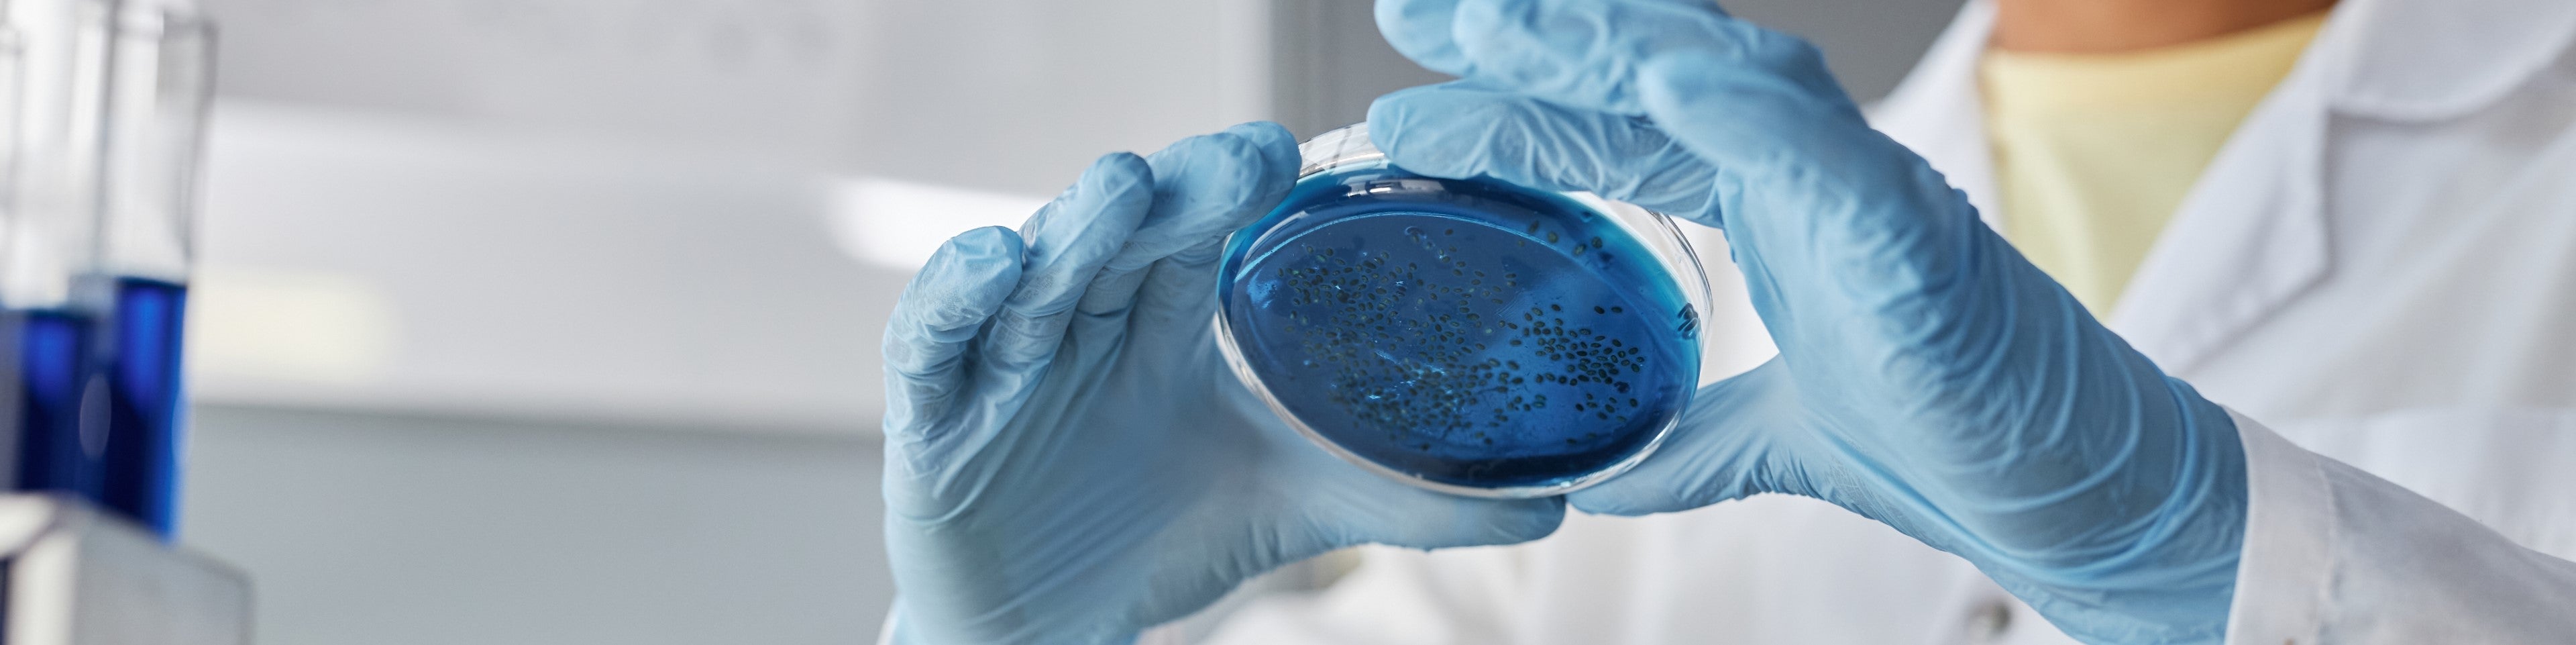

Given the vital role that aptly formulated, premium disinfectants play in combating the spread of infectious disease, and consumers need for guidance in identifying such products, the CDC published "The Properties of an Ideal Disinfectant," a landmark report that reveals the 13 key criteria that constitute an Ideal Disinfectant.

THE 13 PROPERTIES OF AN IDEAL DISINFECTANT
- Broad Spectrum: Should be effective against a wide range of pathogens.
- Fast Acting: Should quickly eliminate harmful bacteria and viruses.
- Unaffected by Environment: Should be effective in presence of organic matter.
- Nontoxic: Should be EPA rated “Category IV” for toxicity, their very lowest rating.
- All-Surface Compatible: Must be both safe and effective on all types of surfaces.
- Lasting Protection: Should provide continuous, lasting antimicrobial protection.
- Easy to Use: Should be easy to use with simple, clear label Directions for Use.
- Odorless: Should have a pleasant odor, or be odor and chemical fume-free.
- Economical: Should not be prohibitively expensive or time consuming to use.
- Water Soluble: Should be water-based, water soluble, and dilutable.
- Highly Stable: Should be stable in all forms and dilution concentrations.
- Effective Cleaner: Should also be an effective, multi-surface cleaner.
- Environmentally Friendly: Should be harmless to the environment.
READ PRODUCT LABELS!
MOST DISINFECTANTS ARE FAR FROM IDEAL, BUT PERMASAFE CLEAN ✓ CHECKS ALL THE BOXES!
Content Source: U.S. Centers for Disease Control and Prevention CDC.gov